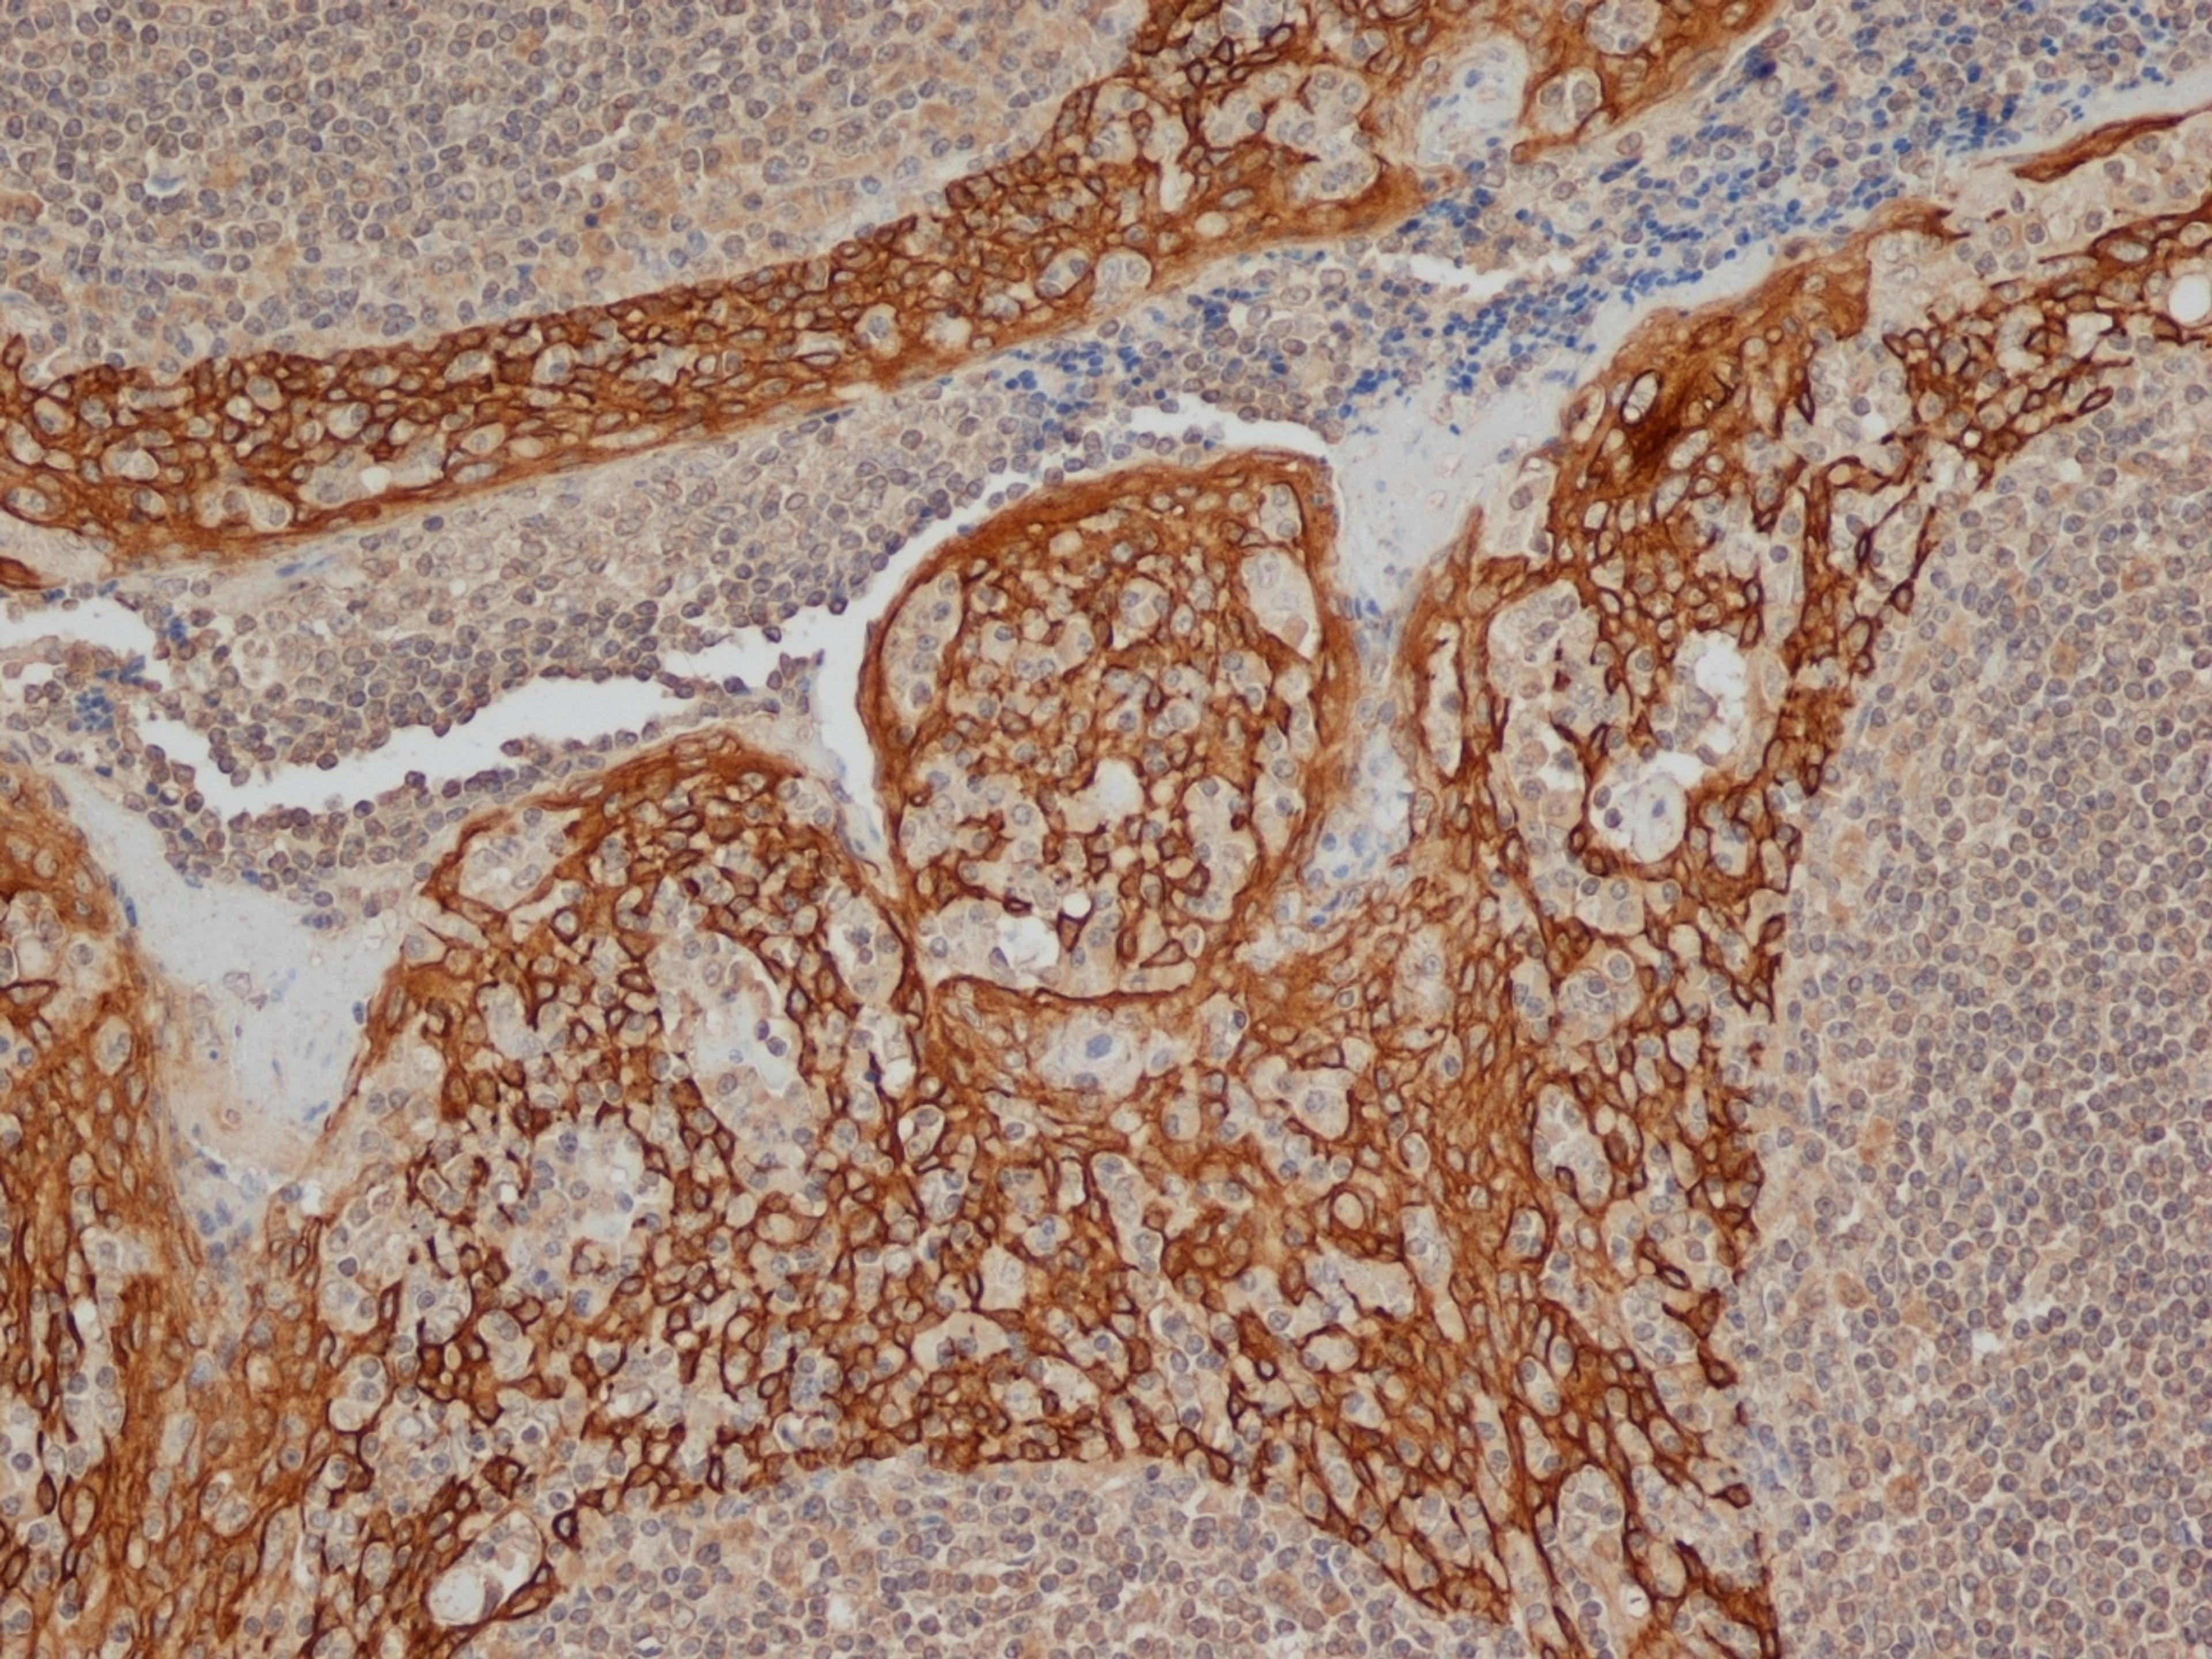
Immunoperoxidase staining of FFPE human tonsil with Mouse anti Human cytokeratin 14

Product & ReviewsAntibodies
MOUSE ANTI HUMAN CYTOKERATIN 14
Product Details
- Cat. No.
- MCA890
- Type
- Primary Antibody
- Clonality
- Monoclonal
- Host
- Mouse

The supplier does not provide quotations for this antibody through SelectScience. You can search for similar antibodies in our Antibody Directory.
Description
Mouse anti Human Cytokeratin 14 antibody, clone LL002 recognizes cytokeratin 14, a type I intermediate filament, expressed by stratifying epithelial cells and can be used to distinguish these cell types from simple epithelial cells, which do not express cytokeratin 14.Mouse anti cytokeratin 14, clone LL002 has been reported to be suitable for use in Western blotting (Alam et al. 2011)
Biological Information
- Clonality: Monoclonal
- Host: Mouse
- Reactivity: Dog (Canine), Elephant, Human, Lion, Pig (Swine)
- Isotype: IgG3
Handling
- Quantity: 0.2 mg
- Storage: +4ºC, -20ºC if preferred
- Buffer: Phosphate buffered saline, 0.09% Sodium Azide
Applications
- Flow Cytometry (FC)
- Immunofluorescence (IF)
- Immunohistochemistry (Frozen Sections) (IHC (Fr))
- Immunohistochemistry (Paraffin-Embedded Sections) (IHC (P))
- Western Blotting (WB)